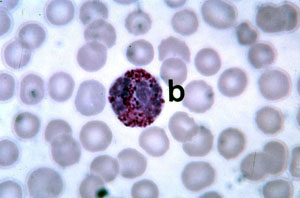
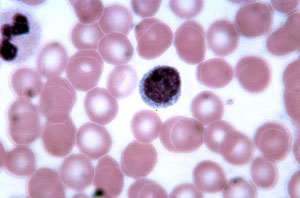
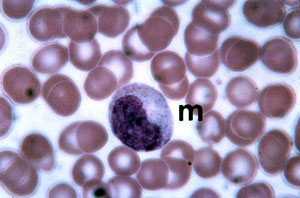
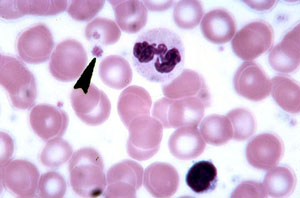
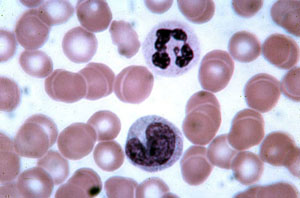

TESUTURILE EPITELIALE
Epiteliile reprezinta o categorie fundamentala de tesuturi care sunt alcatuite tipic din celule strans unite intre ele. Pot prezenta o mare varietate morfologica aspectul fiind de tesut dens cu putina substanta interstitiala. Tesuturile epiteliale se divid in 3 clase majore: epitelii de acoperire, glandulare si senzoriale.
EPITELIILE DE ACOPERIRE
Epiteliile de acoperire si de delimitare se impart in 2 categorii:
Prima este reprezentata de epiteliile unistratificate (epitelii membranare simple);
A doua este reprezentata de epiteliile stratificate, formate din mai mult de un strat de celule.
In stabilirea denumirii epiteliilor de acoperire se iau in consideratie 2 criterii plus cel al morfologiei tipului celular predominant. De exemplu, putem avea un epiteliu simplu scuamos unistratificat , dar si altul stratificat etc.
EPITELIUL SIMPLU SCUAMOS
Capsula Bowman glomerulul renal. Coloratie HE 400x.
Sageata indica epiteliul simplu scuamos, format dintr-un strat unic de celule aplatizate nuclei inmuguriti.

Perete capilar coloratie HE 400x.
Epiteliul intern de delimitare a tuturor vaselor de sange este un epiteliu simplu scuamos si este frecvent denumit endoteliu.

Tubi renali (uriniferi), coloratie HE 400x.
Epiteliul simplu cuboidal este format dintr-un singur strat de celule care, pe sectiune, prezinta aceleasi dimensiuni pe grosime, lungime si inaltime (ca un cub). In imaginea de mai jos, sageata de sus indica membrana bazala, de suport pentru epiteliul simplu cuboidal, in timp ce sageata de jos arata o structura numita marginea "in perie".

Celule hepatice, coloratie HE 400x.
Chiar daca fac parte dintr-o structura glandula 353h72d ra, celulele hepatice (hepatocite) apar morphologic ca un tip de epiteliu cuboidal, cum se vede in imaginea de mai jos, pe sectiune histologica.

Epiteliu germinal ovarian, coloratie HE 400x.
Se observa cum un singur strat de epiteliu simplu cuboidal acopera suprafata libera a ovarului. De aceea se incearca inlocuirea termenului de "cuboidal" cu epiteliu "cuboidal de suprafata".

EPITELIU SIMPLU COLUMNAR
Vezica urinara coloratie HE 400x.
Sectiunile longitudinale ale epiteliilor simple columnare prezinta celule inalte, alungite, prismatice, care au nucleu oval, localizat de obicei la polul bazal al celulei. Epiteliul simplu columnar se sprijina pe o membrana bazala subtire.

Segmentul duodenal al intestinului subtire, coloratie HE 400x.
Ca o caracteristica a epiteliilor simple columnare este prezenta unui singur sir de celule alungit-inalte, prismatice. Sageata din stanga indica marginea striata, in timp ce sageata mai mare se termina la nivelul mucusului secretat de o celula glandulara.

Salpinge (trompa uterina) coloratie HE 400x.
Se observa un epiteliu simplu columnar ciliat. Sageata indica prezenta cililor la suprafata libera a celulelor columnare.

Trahee, coloratie HE 400x.
In imaginea de mai jos apare un epiteliu tipic pseudostratificat columnar al tractului respirator. Se observa prezenta cililor si celulelor secretorii. Sageata indica mucusul ca produs de secretie. Cum acest tip de tesut este format din celule de inaltime diferita, se creaza impresia de falsa (pseudo-) stratificare. Alt aspect caracteristic asociat epiteliilor pseudostratificate columnare din caile aeriene superioare este prezenta unei membrane bazale largi-proeminente.

Epididim, coloratieHE 400x.
Se observa epiteliul pseudostrtificat columnar localizat la nivelul epididimului (parte a aparatului reproducator masculin). Este format partial din celule epiteliale inalte, columnare, a caror suprafata libera prezinta stereocili, asa cum indica sageata.

Vezica urinara, coloratie HE 400x.
Epiteliul tranzitional este o categorie de epiteliu stratificat caracteristic cailor urinare. Aici el tapeteaza vezica urinara, ureterul si portiuni din uretra ca si regiunea pelvisului renal (bazinet). Prezinta o mare variabilitate de aspecte microscopice, adesea celulele de suprafata (sageata) fiind mari-rotunde, ceea ce confera suprafetei libere a uroteliului un model ondulant, neregulat (vezi imaginea de pe pagina urmatoare).

Vezica urinara, coloratie HE 400x.
Mergand in jos de la celulele mari, rotunde, superficiale, observati modificarea morfologiei celulare, care devine neregulat-poliedrica, in zonele intermediare, pana la celule in forma de "para" si in final, in regiunea celulelor bazale unde acestea sunt rotunde sau cuboidale.

EPITELIUL STRATIFICAT CUBOIDAL
Duct (canal excretor) de glanda salivara, coloratie HE 400x.
Epiteliul stratificat cuboidal este relativ rar. In localizarea la ductele glandelor salivare apare format din 2 straturi celulare cu aspect cuboidal.

Retina, coloratie HE 400x.
Stratul extern al retinei prezinta celule incarcate cu un pigment numit melanina. Functional, acest epiteliu pigmentar absoarbe lumina si tinde sa previna reflexia acesteia. In imagine, sageata indica multe granule mari de pigment melanic, brun-negricios.

EPITELIUL STRATIFICAT SCUAMOS NEKERATINIZAT
Esofag, coloratie HE, 100x.
Se observa o membrana epiteliala formata din multe straturi celulare. Celulele superficiale, cele mai aproape de suprafata libera a membranei epiteliale stratificate, sunt aplatizate, scuamoase ca aspect, caracteristica structurala ce confera numele de epiteliu scuamos. Celulele profunde sunt de forma rotunda sau chiar cuboidale. Sageata indica celulele bazale ale acestei membrane epiteliale, care se sprijina pe tesutul conjunctiv de suport.

Epiglota, coloratie Verhoeff' 100x.
Comparati cu precedenta imagine aspectul de mai jos al epiteliului stratificat scuamos nekeratinizat al epiglotei.

EPITELIUL STRATIFICAT SCUAMOS KERATINIZAT
Tegument gros, coloratie HE 400x.
Se poate observa aspectul epitelilui stratificat scuamos recoltat de la tegumentul gros al palmelor sau plantelor. Sageata din portiunea superioara dreapta indica un strat larg de celule epiteliale keratinizate, de aspect aplatizat. In aceasta arie celulele superficiale sunt depletiate de nuclei si sunt reduse la simple scuame cornificate. Straturile mai profunde prezinta celule care variaza ca forma, de la aplatizate-scuamoase la rotunde sau cuboidale bazale. O membrana bazala subtire separa stratul bazal al celulelor epiteliale de tesutul conjunctiv de suport, subjacent.

Piele subtire, coloratie HE 100x
Se observa epiteliul scuamos stratificat keratinizat apartinand pielii din zona abdominala. Se vede stratul superficial de celule cornificate care este considerabil mai subtire decat cel din imaginile anterioare. Sageata indica stratul celulelor bazale ale epiteliului care se sprijina pe mebrana bazala.

GLANDELE UNICELULARE
Structurile epiteliale glandulare sunt clasificate in 2 categorii majore: glande unicelulare si galnde multicelulare. Glandele multicelulare se subdivid in glande exocrine si glande endocrine, adica cu sau fara canal excretor.
Intestin subtire, coloratie albastru alcian 400x.
Iata un exemplu clasic de glanda unicelulara, la nivelul intestinului subtire (si a celui gros) ca si in mucoasa trahheei si bronsiilor. Dupa cum indica sageata, mucusul extras din celulele galndulare secretoare este colorat viu in coloratia albastru-alcian. Portiunea bazala a celulei, ce contine nucleul si citoplasma este relativ stransa pornind de la nivelul membranei bazale. Se observa si mucusul secretat in afara celulei.

Intestin subtire, coloratie Mallory, 400x.
Examinat comparativ cu imaginea precedenta se observa mucusul secretat si morfologia caracteristica a celulelor secretoare.

Glandele simple exocrine
Clasificarea glandelor exocrine multicelulare se bazeaza pe prezenta sau absenta ramificatiilor la nivelul canalelor excretoare si pe aspectul morfologic al portiunii secretorii a glandei. Daca o glanda are un sistem ductal excretor neramificat este o glanda simpla. Glandele cu sistem ductal excretor ramificat se numesc glande compuse. Morfologic, unitatile secretorii ale glandelor multicelulare pot fi tubulare, alveolare, acinare, sau saculare. In mod frecvent produsul de secretie al glandelor multicelulare poate fi mucus (glande mucinoase), sau o substanta filanta numita serozitate (glande seroase).
Tesutul epitelial care formeaza unitatile secretorii impreuna cu sistemul de canale (ducte) excretoare este numit parenchim. Tesutul conjunctiv de sustinere a glandelor, cum ar fi capsulele sau septurile intraglandulare constituie stroma glandei (mezenchimul).
Glanda simpla tubulara dreapta, intestin subtire, 100x.
Un bun exemplu de glanda simpla, tubulara, dreapta este dat de glanda intestinala sau "cripta lui Lieberkuhn" de la tubul digestiv. Sageata din coltul din stanga sus indica orificiul excretor al glandei la nivelul suprafetei externe a mucoasei. Lumenul este mai degraba larg si un mare procent din celulele constitutive ale glandei sunt celule secretoare de mucus. Sageata situata mai jos indica aceste celule glandulare.
Glanda tubulara simpla , tegument, coloratie HE 40x.
Portiunile secretorii si excretorii ale acestei glande sunt dispuse ca niste viermisori. Sageata 1 indica portiunea secretoare palida a glandei, iar sageata 2 indica o mica portiune a ductului excretor, inchis la culoare, care se sprijina pe tesutul conjunctiv al dermului. Sageata 3 arata traiectul ductului excretor prin straturile superficiale, keratinizate ale epidermului.

Glanda simpla tubulara dreapta, intestin subtire, coloratie HE 40x.
Glandele simple tubulare drepte se deschid in lumenul intestinal la baza vilozitatilor intestinale.

Glanda simpla tubulara, piele groasa, coloratie HE
100x.
Se observa portiunea secretorie a glandei si ariile mai profunde ale canalelor excretoare. Portiunea secretorie a glandei este colorata in roz-pal. Sageata indica aceasta structura acestei regiuni. Ductele excretorii au un lumen mai mare ca regiunea secretorie iar celulele lor sunt mai inchis colorate.

Glanda simpla ramificata saculara asociata foliculului pilos din tegument, coloratie HE 400x. Aceasta prezinta la obiectivul mare (400x) morfologia celulara tipica a unitatilor secretorii acinare. Datorita continutului lipidic celular citoplasma are aspect bogat vacuolat (vezi imaginea de pagina urmatoare).

Glanda simpla ramificata tubulo-acinara, trahee,
coloratie HE, 100x. Cum se observa dupa ce indica sageata in imagine
exista ducte simple sau neramificate care colecteaza produsul de
secretie in lumenul traheei dintr-o
serie de unitati secretoare, care devin coalescente in functie
de canalele excretoare neramificate.

Glande tubulare simple, piele groasa, coloratie HE 100x.
Cu un obiectiv mai puternic se observa ductee excretoare ale unei glande tubulare simple. Sageata de sus indica traiectul ductului excretor prin stratul cornos al epidermului. Sageata de jos indica o portiune a canalului excretor care strabate tesutul conjunctiv al dermului pana in straturile bazale epiteliale ale epidermului.

Glanda tubulara compusa, rinichi, coloratie HE 100x.
La aceasta marire morfologia tubulara este mai greu de observat. Dupa cum indica sageata se vede un nou exemplu a portiunii ramificate a sistemului ductal.

Glanda compusa tubulara, glandele Brunner, coloratie Mallory 400x.
La o marire mai mare unitatile secretorii tubulare secretorii si ramificatiile sistemului ductal devin evidente.

Ducte intralobualre, glanda parotida, coloratie HE 400x.
Indicat de sageata avem o sectiune transversala a canalelor intralobulare. Aceste ducte sunt cateodata denumite "ducte striate" sau "ducte secretorii". Lumenul este delimitat de un epiteliu simplu columnar, care are adesea un aspect striat,radial. Se poate remarca si structurile acinare secretoare inconjuratoare, formate exclusiv din celule de tip seros.

Acini mucosi, glanda submandibulara, coloratie HE 400x.
In glandele mixte salivare, adica in cele cuprinzand atat acini serosi cat si mucosi celulele mucose acinare sunt adesea palid colorate. Acesta este intr-adevar cazul structurilor mucoase acinare indicate de sageata. De notat citoplasma care apare foarte palida si nucleii localizati la polul bazal al celulei.

Acini mucosi, glanda submandibulara, coloratie HE 400x.Iata un alt exemplu de reactie de colorare a acinilor formati din celule mucoase comparativ cu celulele seroase. Celulele mucoase indicate de sageata sunt clar colorate in roz (eosinofile) comparativ cu aspectul granular, bazofil al celulelor seroase adiacente. De notat ca acinii mucosi prezinta practic acelasi lumen care a fost observat in imaginile de mai sus care se refereau la acinii serosi.

Glanda compusa submandibulara, coloratie HE 40x.
Glandele submandibulare, parotide sau sublinguale sunt un bun exemplu de glande compuse acinare. Iata un aspect de ansamblu in care se observa un duct interlobar, ducte interlobulare, ca si acini, atat serosi cat si mucosi.

Glande sacciforme compuse, glanda mamara activa, coloratie
HE 100x.
Se observa cateva unitati secretorii, iar sageata indica lumenul larg al acestor unitati.

Glanda compusa sacciforma, mamela, coloratie HE 400x.
La o marire mai mare se observa detalii ale unitatii secretorii extinse. Sageata indica lumenul larg.

Acini serosi, glanda parotida, coloratie HE 400x.
In centru se observa un lumen acinar de mici dimensiuni. Sageata indica acinul seros si lumenul sau central. Celulele seroase au un aspect oarecum granular al citoplasmei. In glanda parotida exista numai acini serosi.

GLANDELE ENDOCRINE |
||
|
|
Aspectele structurale care sunt commune majoritatii glandelor endocrine sunt la fele de importante ca si cele specifice si vor fi descries in detaliu mai jos in cele ce urmeaza. |
|
Glanda endocrina
Adenohipofiza, coloratie HE 100x.
Glandele endocrine sunt caracterizate prin absenta canalelor excretoare. Sectiunea prezinta cuiburi sau siraguri de celule care isi varsa direct produsul de secretie (hormon) in curentul sanguine. Chiar la o marire mica a obiectivului este evidenta bogata vascularizatie a acestei glande. De notat asocierea celulelor parenchimului cu canalele vasculare sanguine cu perete subtire.

Glanda endocrina
Adenohipofiza coloratie HE 400x.
La o marire mai mare a obiectivului se observa detaliile structurale specifice ale glandei endocrine. Exista cateva tipuri de celule parenchimatoase secretoare care se sprijina pe o retea fina de fibre conjunctive. De notat ca celulele secretorii se afla in stransa asociere cu peretii subtiri ai vaselor de sange ale organului, asa cum indica sageata.

Impreuna cu tesutul epitelial muscular si nervos face parte din cele 4 categorii de tesuturi de baza sau fundamentale. Tesutul conjunctiv se caracterizeaza prin abundenta de substanta intercelulara sau matrice. Tesutul conjunctiv este format din 3 entitati structurale: substanta fundamentala, fibre si celule. Substanta fundamentala este adesea dificil de demonstrat histologic, de obicei prezentandu-se sub forma unui precipitat fin granular. Vom prezenta intai componentele fibrilare si apoi celulele iar apoi vom revedea variatele tipuri de tesut conjunctiv.
Fibre colagene
Tesut conjunctiv moale areolar coloratie HE 400x.
Fibrele colagene din imagine sunt acidofile (rosii sau roz) si isi iau culoarea din componenta eosinica a tehnicii de colorare. Colagenul apare in structuri de diametru grosime si aranjament diferit. Sageata din portiunea centru-dreapta indica un ghem destul de voluminous de fibre colagene.
Fibrele oxitalanice
Ligament periodontal, tehnica cu fucsina 100x.
Fibrele oxitalanice indicate de sageata sunt distribuite neuniform, dar concentrate in anumite zone, una dintre ele fiind ligamentul periodontal care fixeaza dintele. In imagine litera P indica ligamentul periodontal iar litera C cementul, in timp ce litera D indica dentina.
Fibrele oxitalanice
Ligament periodontal, tehnica cu fucsina 400x.
Examinat la un obiectiv mai puternic fibrele oxitalanice purpurii indicate de sageata sunt dispuse printre cele galben-oranj de colagen ale ligamentului periodontal.
Celulele tesutului conjunctiv:
Fibroblaste
Tesut conjunctiv lax areolar, coloratie HE 400x.
Cea mai frecventa si importanta categorie de celule conjunctive sunt fibroblastele de forma spinoasa sau fuziforma, alungite, mari cu nuclei palizi de forma ovala. Adesea citoplasma si ea palida este putin evidenta fiind mascata de fibrele colagene.
Tesuturile conjunctive fibroase moi
De notat morfologia fuziforma a fibroblastilor si aspectul delicat al fibrelor colagene
Tesutul conjunctiv mezenchimal
Tesut conjunctiv embrionar, brat de embrion, coloratie HE, 100x. Asemanator ca aspect cu tesutul conjunctiv mucos, cu abundenta substanta fundamentala, fibrele fine colagene si fibroblastii stelati sau fuziformi sunt prezenti si in acest tip de tesut. Sectiunile, asa cum se indica de catre sageata adesea prezinta capilare sanguine cu perete subtire (vezi imaginea de pe pagina urmatoare).
Tesut conjunctiv fibros lax
Tesut areolar moale, submucoasa intestinala, coloratie HE 100x . Tesutul conjunctiv areolar poseda toate componentele mentionate anterior, adica: fibre colagene,elastice si reticulare; fibroblasti, macrofage, mastocite, plasmocite si leucocite; substanta fundamentala amorfa. Fibrele de colagen sunt cele care predomina, in timp ce fibroblastii sunt tipul celular cel mai des intalnit in acest tesut.
Tesuturile conjunctive dense fibroase interstitiale
Tesut conjunctiv dens fibros interstitial glanda mamara inactiva, coloratie HE 100x Asa cum se indica de sageata stroma interlobulara a glandei mamare inactive este formata din tesut conjunctiv dens interstitial. Fibrele groase de collagen dispuse in manunchiuri cu aranjament neregulat formeaza stroma tesutului. Fibroblastii formeaza majoritatea componentei celulare, putine macrofage fiind prezente.
Tesut conjunctiv fibros dens elastic, perete de arteriola, coloratie Verhoeff 400x Sageata indica o structura specializata numita "lamina interna" elastica a tunicii musculare la o arteriola. Structura e compusa din fibre elastice strans compacatate.
Tesut conjunctiv fibros dens elastic, perete de arteriola, coloratie Verhoeff 400x
In peretele arterelor elastice mari, cum ar fi aorta, exista benzi concentrice de fibre elastice dense, compacte, regulate care adauga rezistenta si elasticitate peretelui vascular. .

Se poate examina structura laminei elastice dens aranjate, compacte, in peretele aortei.

Tesutul conjunctiv reticular este format din celule reticulare (reticulocite) si o retea delicata de fibre reticulare, care formeaza ramificatii ce reprezinta suportul pentru celulele ganglionului limfatic. In afara de stroma delicata a organelor limfoide, tesutul conjunctiv reticular se gaseste si in maduva osoasa hematopoietica.

Tesut conjunctiv adipos, tesut subcutan, coloratie HE 40x.
In contrast cu alte tesuturi cum ar fi cel conjunctiv fibros componenta majora a functionala a a tesutului adipos este reprezentata de celula grasa (lipocit). Celulele grase (indicate de sageata) sunt strans impachetate si se sprijina pe colagen fin si pe celule reticulare ca si pe fibrele mai dure de colagen. Pe aceasta sectiune, pe durata prelucrarii piesei, solventii au indepartat materialul lipidic din celulele grase.

Tesutul conjunctiv adipos, tesut subcutan, coloratie HE 400x.
Cum indica sageata nucleii celulelor grase sunt impinsi la periferie de catre vacuolele de grasimi. Citoplasma adipocitelor este redusa la o banda subtire in jurul periferiei celulare. Citoplasma sa palida delimiteaza vacolele de lipide.

Grasime bruna, tesut fetal, coloratie Mallory 100x.
Grasimea bruna este o froma de tesut adipos in care mici picaturi lipidice isi pastreaza individualitatea, adica nu conflueaza intr-o singura vacuola de grasime (asa cum este cazul celulelor grase apartinand grasimii albe, prezentate in imaginile anaterioare).


Eritrocite si neutrofile
Frotiu sange periferic 950x
Eritrocitul (hematia) este un disc bicocncav anucleat care se coloreaza in roz. In zona sa centrala poate adera de alt eritrocit si sa formeze rozete. Neutrofilele sunt mai mari, au nucleu central multilobat si o citoplasma palida. In partea de jos a imaginii este un monocit.

Eosinofilul
Frotiu de sange periferic 950x
Zona centrala este ocupata de un leucocit numit eosinofil. De notat prezenta in aceasta celula a unui nucleu lobat si a unei citoplasme granulare care se coloreaza in roz-pal. De comparat cu afinitatea tinctoriala a neutrofilelor din imaginea precedenta.

Bazofilul
frotiu de sange periferic 950x
Bazofilul notat cu litera "b" este un leucocit cu nucleu polilobat si caracterizat prin prezenta unui mare numar de granule inchise la culoare (bazofile) intracitoplasmatice care pot uneori masca nucleul.
Frotiu de sange periferic 950x
Monocitul
Este mai mare ca limfocitul, cu nucleu mare si inegal colorat, citoplasma abundenta si cu granule.
Plachetele sanguine
Frotiu de sange marire 950x.
Se pot observa cateva plachete sanguine in aceasta imagine (una dintre ele este indicata de sageata). Aceste llachete au putina citoplasma si au forma neregulata.

Plachetele sanguine
Frotiu de sange 950x
Asa cum arata sageata micul fragment de citoplasma constituie un trombocit. In portiunea centrala a imaginii exista un neutrofil iar in cadranul inferior drept se observa un limfocit.
Eritrocite si leucocite
Frotiu de sange 950x .
De revazut caracteristicle eritrocitului comparativ cu ale leucocitului.
Elemente figurate intr-o artera mica
Coloratie HE 400x.
Imaginile atrag atentia asupra aspectului celulelor din sangele periferic pe un vas sectionat. De notat ca eritrocitele si leucocitele sunt usor de diferentiat, ca si neutrofilele si limfocitele pe baza structurii lor nucleare.


Hemopoieza (formare de elemente figurate)
Maduva osoasa coloratie HE 400xn 400x.
Exista multe tipuri de cellule in diferite stadii de dezvoltare. Celula amre centrala indicata de sageata este un megacariocit .

Hemopoieza
Maduva rosie osoasa, coloratie HE 600x
La un obiectiv mai puternic se observa elemente figurate in diferite etape de dezvoltare, in coltul stang de sus se observa un megacariocit (indicat de sageata), ca o celula de mari dimensiuni.

|